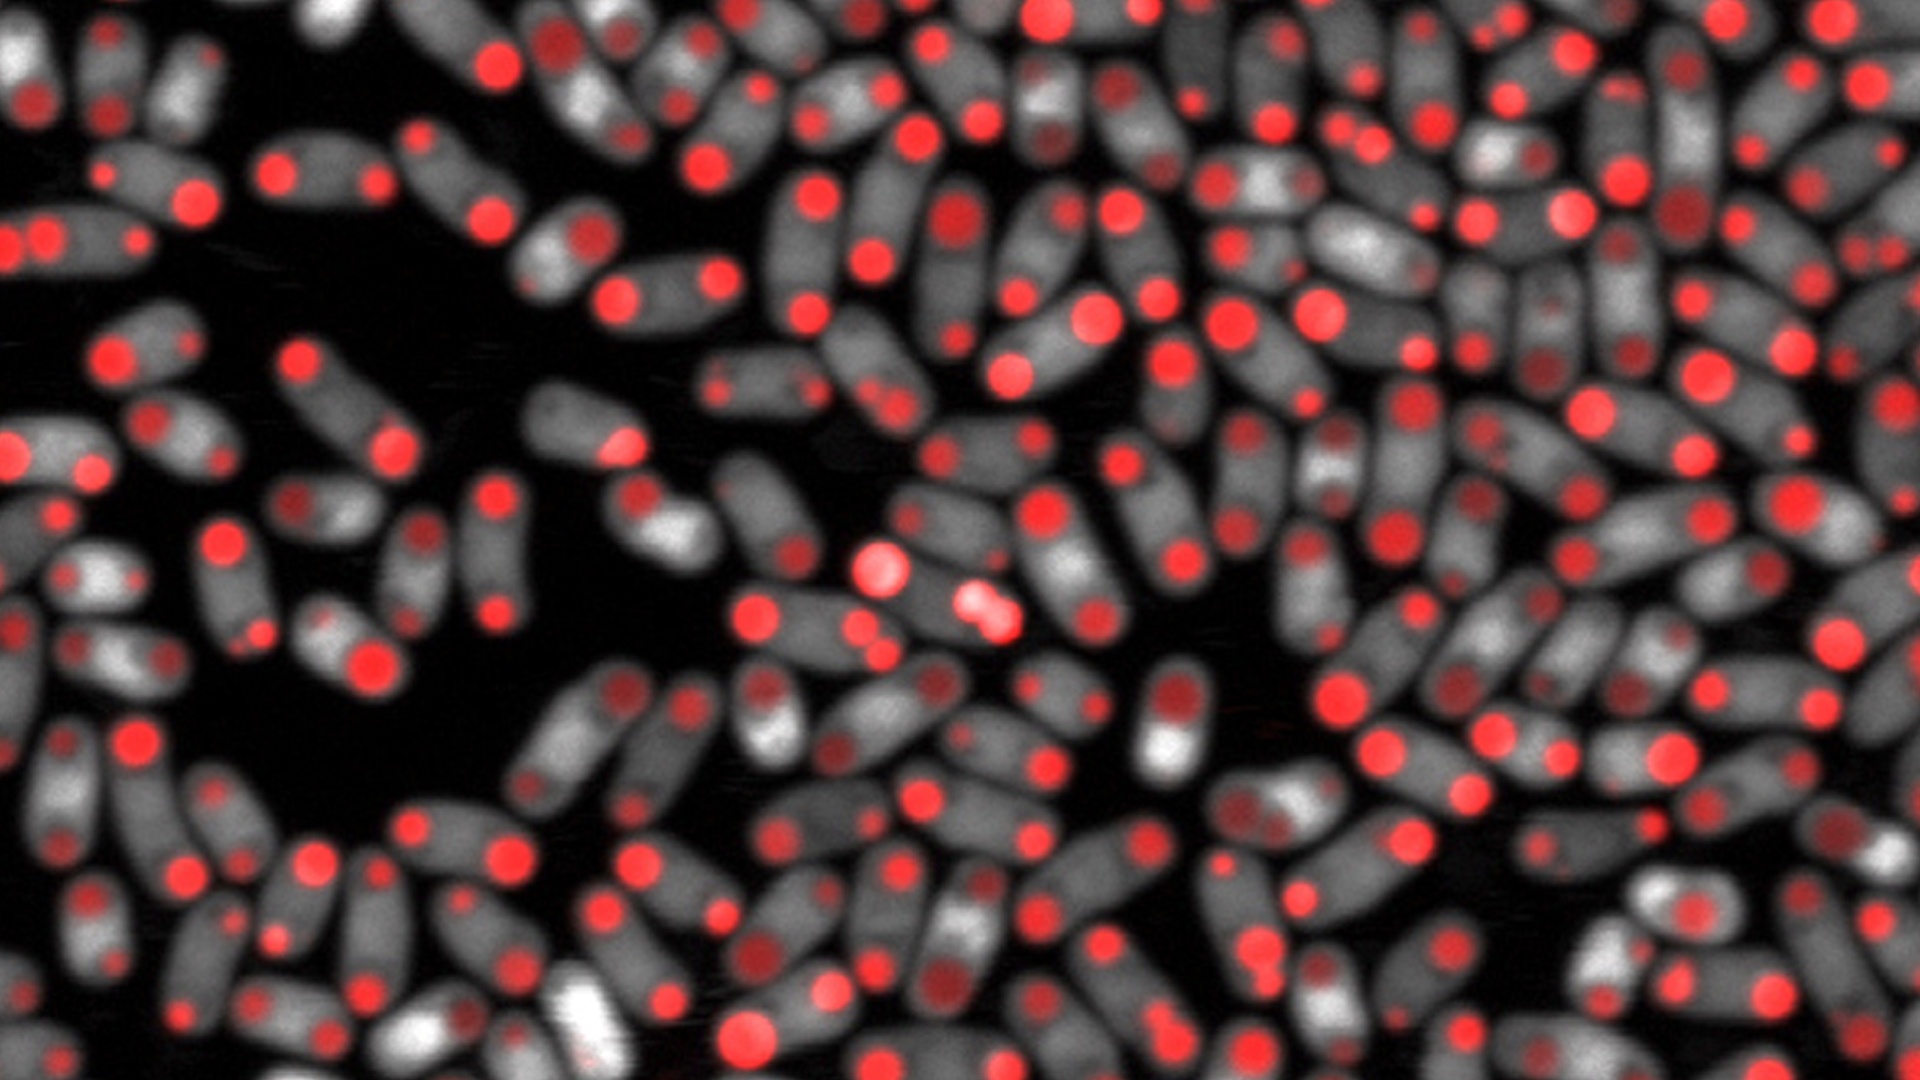

Tutkimuksen lähtökohtana oli ymmärtää, miten männyn ja bakteereiden välinen yhteiselo toimii. Kasvit ja eläimet puolustautuvat mikrobeja vastaan, olivatpa ne sitten hyviä tai pahoja. Ne tuottavat suuria määriä happiradikaaleja infektiokohtaan estääkseen mikrobien pääsyn eteenpäin.
Bakteerit ovat kehittäneet oman suojautumistavan happiradikaaleja vastaan. Bakteerien runsaana energiavarastona toimivan pitkän rasvahappoketjun, polyhydroksibutyraatin, havaittiin yllättäen toimivan antioksidanttina, kun se oli pilkottuna pieniin osiin.
Bakteerit kykenevät tuottamaan rasvahappoketjua todella suuria määriä, jopa 90 prosenttia solun massasta. Tämä kuvastaa miten tärkeä yhdiste on bakteerille silloin, kun antioksidanttia tarvitaan nopeasti suuria määriä.
Tiedon avulla voidaan etsiä sellaisia antibiootteja, jotka tuhoavat bakteereilta kyvyn tuottaa pitkää rasvahappoketjua.
Osana tohtorikoulutettava Janne Koskimäen kasvimikrobiologian alaan kuuluvaa väitöskirjaa, tutkimus osoitti tämän suojautumistavan olevan erittäin laajalle levinnyt bakteerikunnassa ja liittyvän yleisesti bakteerien kykyyn sietää vaikeita olosuhteita.
Tutkimuksessa havaittiin, että bakteerien energiavaraston hajotusprosessissa syntyneet lyhyet rasvahappoketjut hävittivät hapen myrkyllisintä muotoa, hydroksyyliradikaalia, jopa kolme kertaa tehokkaammin kuin tunnetuin solujen luonnollinen antioksidantti, glutationi, ja peräti yli kymmenen kertaa paremmin kuin C-vitamiini. Yhdisteiden havaittiin suojaavan myös hiivasoluja hapettavilta olosuhteilta.
Tutkimuksen tulokset julkaistiin 14. maaliskuuta 2016 Nature Chemical Biology-lehdessä.
Saatuja tuloksia hyödynnetään parhaillaan Oulun yliopistossa käynnissä olevassa Tekesin TUTLi (tutkimuksesta uutta tietoa ja liiketoimintaa)-rahoitteisessa hankkeessa, jossa kehitetään hoitomuotoa silmänpohjanrappeumaan. Suomen Akatemia on tukenut Koskimäen tutkimusta.
Juttu perustuu käytännössä kokonaan Oulun yliopiston viestinnän artikkeliin, jonka on kirjoittanut Maarit Jokela.